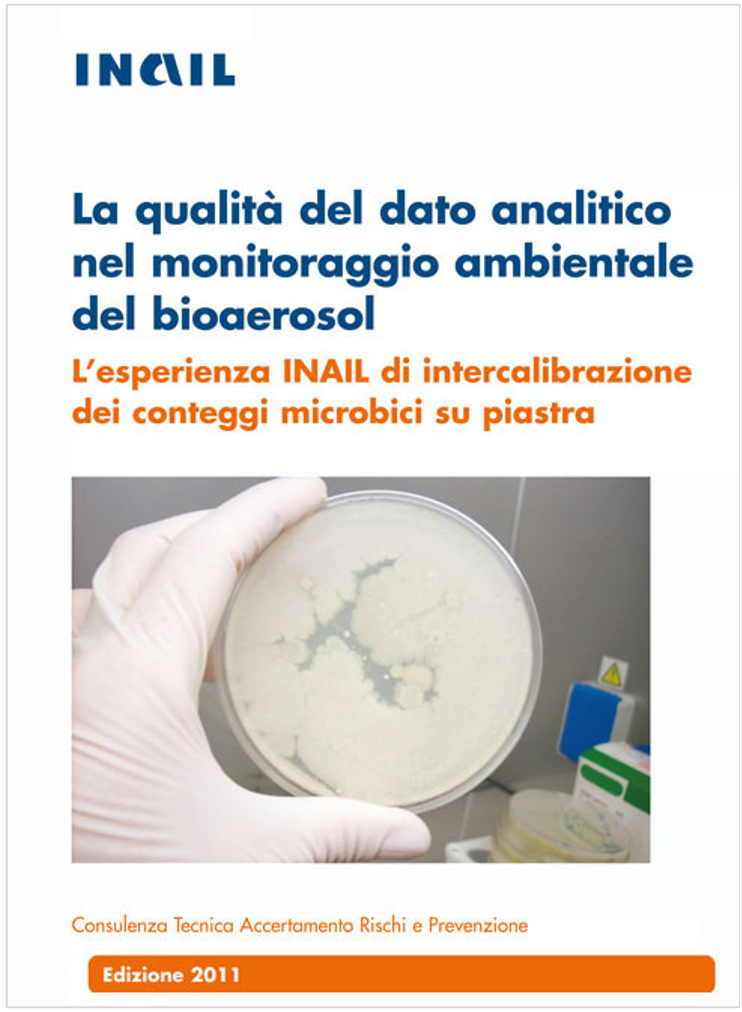
La qualit del dato analitico nel monitoraggio ambientale del bioaerosol La qualit del dato analitico nel monitoraggio ambientale del bioaerosol

La qualità del dato analitico nel monitoraggio ambientale del bioaerosol
| ID 21519 | | Visite: 1157 | Guide Sicurezza lavoro INAIL | Permalink: https://www.certifico.com/id/21519 |
La qualità del dato analitico nel monitoraggio ambientale del bioaerosol
ID 21519 | 16.03.2024 / INAIL 2011
Il prodotto presenta gli esiti innovativi di un'attività sperimentale condotta, nell'arco di cinque anni, dalla CONTARP in collaborazione con la CSA e con l'ARPA Liguria (Dipartimento di Genova - U.O. Laboratorio, Settore Biologia), nel campo del rischio biologico occupazionale.
Nell'ambito di tale attività è stato validato un percorso di standardizzazione interna e un modello statistico per il miglioramento della qualità dei dati analitici relativi alla misura del bioaerosol negli ambienti di lavoro.
...
Fonte: INAIL
Collegati
Valutazione rischio biologico nelle attività istituzionali delle Agenzie per la Protezione dell’Ambiente
Check list verifica applicazione rischio biologico Titolo X D.Lgs. 81/2008
Valutazione del rischio biologico / Algoritmo valutazione esposizione AB
Applicativo Valutazione del rischio biologico INAIL
Il monitoraggio microbiologico negli ambienti di lavoro
Il rischio biologico nei luoghi di lavoro - INAIL
| Descrizione | Livello | Dimensione | Downloads | |
|---|---|---|---|---|
| La qualità del dato analitico nel monitoraggio ambientale del bioaerosol.pdf INAIL 2011 |
12336 kB | 24 |
Tags: Sicurezza lavoro Rischio biologico Abbonati Sicurezza Guide Sicurezza INAIL